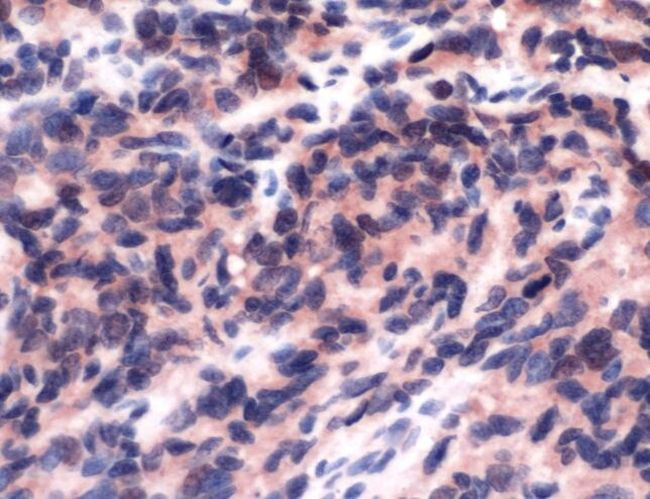
FLI1 Antibody in Immunohistochemistry (IHC)

Search
Invitrogen
FLI1 Polyclonal Antibody
{{$productOrderCtrl.translations['antibody.pdp.commerceCard.promotion.promotions']}}
{{$productOrderCtrl.translations['antibody.pdp.commerceCard.promotion.viewpromo']}}
{{$productOrderCtrl.translations['antibody.pdp.commerceCard.promotion.promocode']}}: {{promo.promoCode}} {{promo.promoTitle}} {{promo.promoDescription}}. {{$productOrderCtrl.translations['antibody.pdp.commerceCard.promotion.learnmore']}}
产品信息
PA5-32406
宿主/亚型
分类
类型
抗原
偶联物
形式
保存条件
运输条件
RRID
产品详细信息
This antibody is predicted to react with mouse and rat based on sequence homology.
Heat-mediated antigen retrieval is recommended prior to staining, using a 10mM citrate buffer, pH 6.0, for 10 minutes followed by cooling at room temperature for 20 min. Following antigen retrieval, incubate samples with primary antibody for 30 min at room temperature. A suggested positive control is angiosarcoma, Ewing's sarcoma or placenta tissue.
靶标信息
ETS-1 is the prototype member of a family of genes identified on the basis of homology to the v-Ets oncogene isolated from the E26 erythroblastosis virus. This family of genes currently includes ETS-1, ETS-2, ERG-1, ERG-2, ELK, E74, FLI-1, PU. 1 and PEA3. Members of the ETS gene family exhibit varied pattern of tissue expression, and share a highly conserved carboxy terminal domain containing a sequence related to the SV40 large T antigen nuclear localization signal sequence.
仅用于科研。不用于诊断过程。未经明确授权不得转售。